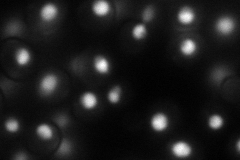
YPL228W
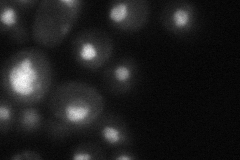
YPL228W

View description
Beta (RNA 5'-triphosphatase) subunit of the mRNA capping enzyme, a heterodimer (the other subunit is CEG1, a guanylyltransferase) involved in adding the 5' cap to mRNA; the mammalian enzyme is a single bifunctional polypeptide
Localization:
Intensity:
Fold change:
Significance:
-
C’ GFP library in SD

below threshold18.11 -
N' NOP1pr-GFP in SD
nucleus67.6037 -
N' TEF2pr-mCherry in SD

nucleus66.6504 -
N' NATIVEpr-GFP in SD
nucleus42.2533 -
N' TEF2pr-VC and Cyto-VN in SD

nucleus41.3254 -
C’ GFP library in SD+DTT

cytosol13.760.75No -
C’ GFP library in SD+H2O2

cytosol16.750.92No -
C’ GFP library in Starvation Media

cytosol14.330.79No -
C’ GFP library on the background of Pup2-DaMP

below threshold -
C’ GFP library on the background of CCT mutant

below threshold19.14311.05693No
